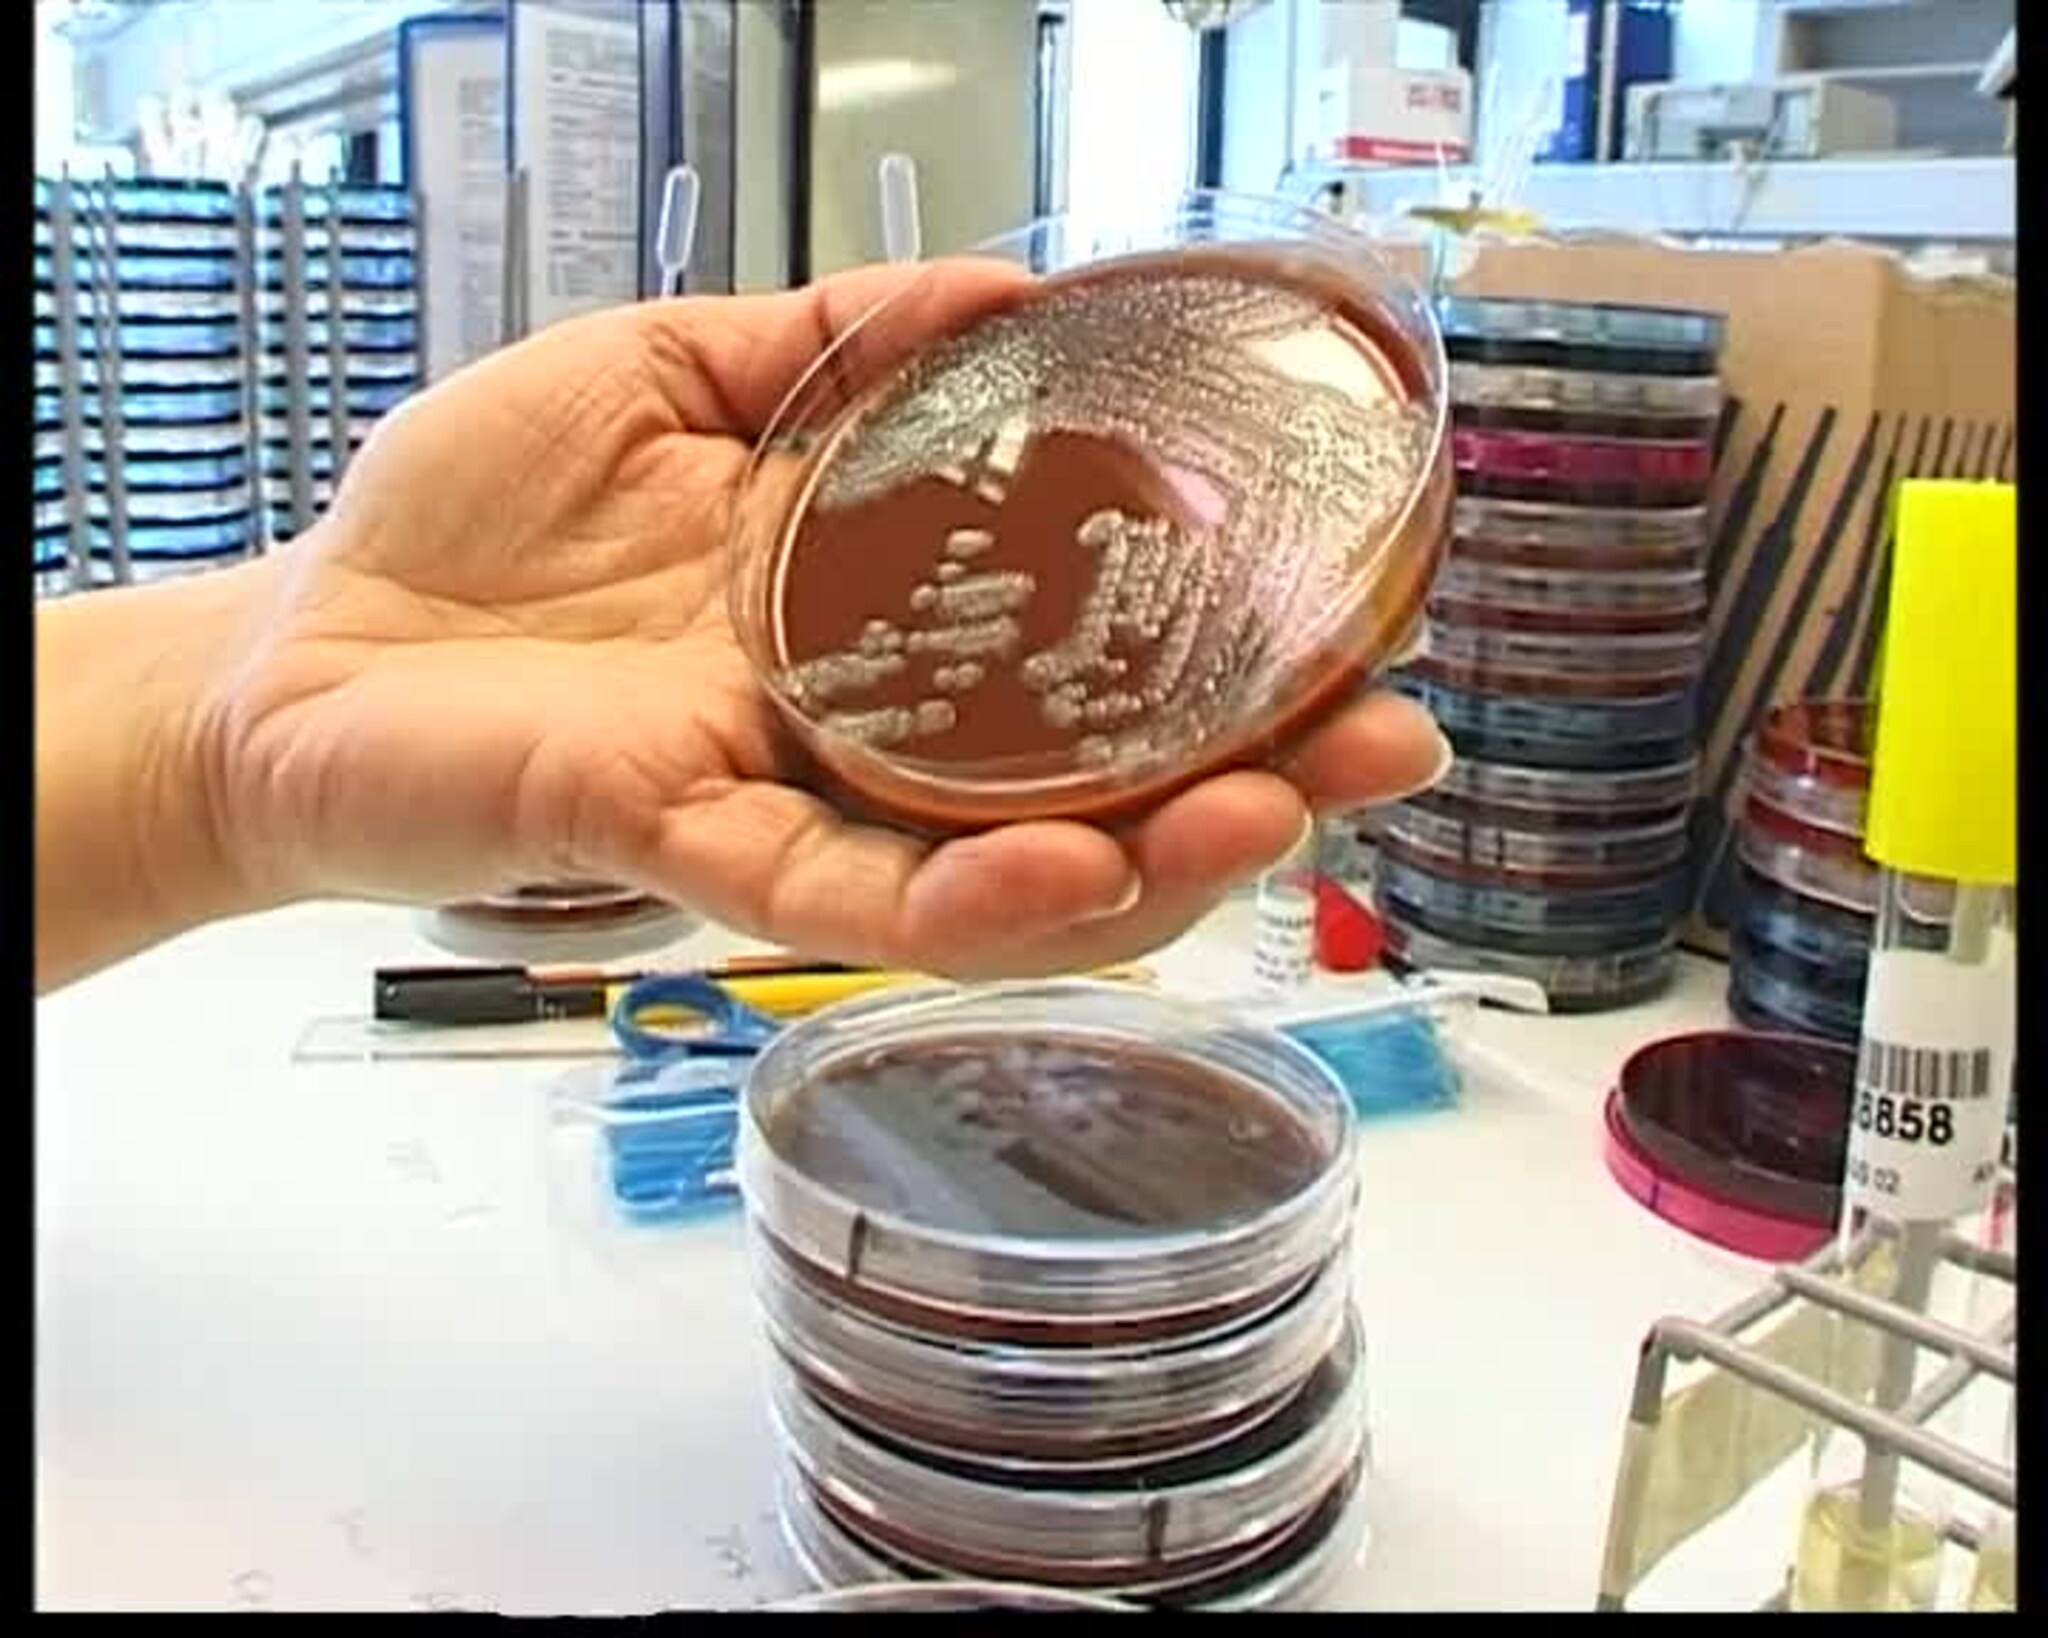
TVSør 17.04.2002

TVSør 17.04.2002
* 0.50: Hagestad * 1.50: Nye Bakterier funnet * 3.18: Snøgg-pressekonferanse * 4.59: Antikk * 7.11: Boplikt * 7.41: Knart-tilståelse * 8.11: Beslag + hotellstreik * 8.56: Hotell-streik * 10.25: Gassfelt * 14.25: Været * 17.55: Kunstnermagasin * . I dag ble streiken i Hotell og Restaurantnæringen utvidet blant annet med Clarion Ernst Hotell og Raddisson SAS Caledonien hotell i Kristiansand. Caledonien stenger under konflikten, menst Ernst forsøker å holde åpent med uorganiserte. Streiken har så langt forløpt rolig. I innslaget: Reporter og fotograf Bjørn Enes; Anette Sørebø, streikevakt / klubbleder; Simon Nahery, streikevakt; Solvår Slaughter, streikevakt / fagforeningsleder * Nye bakterier funnet Det er funnet bakterier i Snøggs munnpenseler helt tilbake til 1997. Det kom frem da mikrobiologisk avdeling på Vest-Agder sykehus testet et stort utvalg av Dent-o-sept fra sitt lager. Dette dreier seg imidlertid om en annen og mindre farlige bakterie. I innslaget: Christian Wulff, reporter og fotograf; Peter Csango, overlege mikrobiologisk avd VAS * Sykkelkarusellen Endelig har årets sykkelkarusell startet. For sykkelentusiaster var gårsdagens Ålefjærrunde et etterlengtet sykkelritt, og hele 95 syklister hadde funnet fram landeveissykkelen til den 32 km lange løypa. Og noen ble ønsket spesielt velkomne. I innslaget: 10:45 Reporter & fotograf: Øyvind Gravås; 11:27 Birger Hafslund; 11:36 Anne Gro Hansen, Vinner av dameklassen * . Kristiansands første store boligprosjektet med innlagt gasstilførsel til hvert hus, skal nå bygges på Søm. For boligutbyggerne, Block Watne, er dette en bevisst komfort- og miljøsatsning. I innslaget: Hanne Lindblom Severinsen, reporter og fotograf; Geir Arne Gundersen, salgskonsulent Block Watne as; Øystein Holvik, plan- og miljøsjef, Kr.sand kommune * Snøgg-rapporten ferdig Allerede i 1999 ble det oppdaget bakterier i væsken som tilsettes munnpenslene fra Snøgg. Men bedriften fulgte ikke opp de anbefalte tiltakene for å bli kvitt problemet. Det går frem av rapporten som som idag ble legt frem for helsministeren. I innslaget: Christian Wulff, reporter og fotograf; Kristian Hagestad, fylkeslege Vest-Agder * Norges største håndballturnering Med hele 300 påmeldte lag, var det norges største håndballturnering som ble arrangert i Kristiansand i helga. De fleste har vært med før, for turneringa har vært et årlig høydepunkt for både lokale og tilreisende håndballspillere helt siden starten for 26 år siden! I innslaget: : Reporter & fotograf: Øyvind Gravås; 05:21 Tore Kolberg, turneringsleder